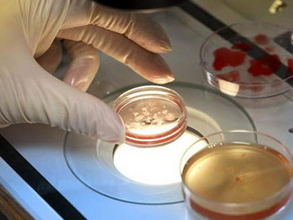

试管婴儿只是一个俗称,它的全称是体外受精——胚胎移植技术,或称为辅助生殖技术。这种技术就是把妻子的卵子和丈夫的精子取出来,在体外形成受精卵,并培养成早期胚胎后,再送回到妻子的子宫,在母体内正常生长发育。

哪些情况适合做试管婴儿
试管婴儿最初是针对输卵管阻塞导致不孕的女性。这些女性不能自然受孕,就用试管代替她们的输卵管,因此叫试管婴儿。
随着技术的发展,由于排卵障碍、子宫内膜异位症、免疫、宫颈或不明因素导致不孕的女性,也可以借助试管婴儿怀孕。
有些女性反复流产,检查时发现夫妇一方染色体不正常,还有些人患有遗传性疾病。这些情况也可以通过试管婴儿技术,先筛选出合格的胚胎,然后再怀孕。这样可以减少流产风险,保证孕育出健康的孩子。
另外,有些妻子无法怀孕,是由于丈夫患有少弱精症、无精子症等影响生育的疾病。这类男性精液里的精子数量少、质量差,甚至根本没有,但睾丸或者附睾当中可以发现精子。通过试管婴儿,可以帮助这样的夫妻怀孕。哪种情况不能做试管婴儿
对生育有要求的适龄夫妇,能够提供精子和卵,又有好的子宫可以孕育胚胎,这是最基本的条件。如果年龄已经不适合生育,不能提供足够数量和质量的精子和卵,试管婴儿的成功率不高,甚至不能做试管婴儿。
由于国内不允许代孕,所以没有子宫的女性肯定做不了试管婴儿。有些虽然有子宫,但子宫内膜受损,不能给胚胎提供着床的必备条件,可能反复做几次都不成功,也需要谨慎考虑是否放弃。
有些严重的急性生殖道传染性疾病,比如梅毒、淋病等性传播疾病,可能在孕育过程中造成宫内传染,绝对不可以做试管婴儿。如果急性期疾病治好了,体内已经产生了抗体,可以考虑做试管婴儿。
男性不育和女性不孕,做试管婴儿的方法相同吗
试管婴儿的基本技术就是体外受精,使精子和卵子在体外结合,再把受精卵在体外培养形成早期胚胎,移植到母体内。
如果是因为女性不孕,男方的精子正常,就用最传统的常规受精方法,将取出的精子和卵一起培养,使其直接自然结合成受精卵,再培养3天形成胚胎,然后移植。
如果男性有严重的少弱精症,需要人工在显微镜下把好的精子挑出来,再通过显微注射的方法将精子注射到成熟后的卵细胞中,这也叫显微受精。受精卵形成胚胎后,再移植到母体内。
患有无精症的男性,如果从附睾或睾丸里能取出精子,将精子一个一个注射到卵细胞中,再继续培养。

做试管婴儿前需做哪些检查
要做试管婴儿的夫妻,应该是被诊断患有不孕不育的夫妇。
但不是所有不孕不育都要做试管婴儿,要找到原因,根据病因进行治疗。或者说实施试管婴儿,应该掌握好适应症,按不同患者的情况具体分析。
首先所有诊断不孕的女性都要了解一下月经周期是否正常,如果过长或者过短可能提示排卵异常,这些女性需要检查性激素水平。
试管婴儿的绝对适应症是输卵管堵塞。做什么检查可以发现输卵管不通呢?最常用的方法是子宫输卵管碘油造影,它的准确性比较高。腹腔镜下的输卵管检查和通液试验是诊断输卵管是否通畅的金标准,其中通液试验需要微创手术。在检查女方输卵管是否通畅之前,要先查男方精液是否正常。如果精液有问题,女性暂时可以不检查。
当确定是输卵管性不孕或者男性不育后,如果符合做试管婴儿适应症,要给夫妻双方做常规的体检。目的是保证夫妻双方有好的身体,而且女性能够承受怀孕,可以生出健康的宝宝。体检项目包括肝肾功能、胸片(排除肺部感染及其他疾病)、心电图,以及微生物的免疫检查(如乙肝、丙肝、梅毒、艾滋病等)。

为什么要促排卵它的作用是什么
试管婴儿是要做卵的体外受精。正常情况下,女性每个月经周期只排一个卵,而且是靠生理周期决定卵子排出的时间。这个具体的时间我们很难准确预测,要在自然周期内把成熟度适当的卵取出来是很难的。而且即使取出来,一般只有一个合适的卵,成功率也比较低。
通过药物促进女性同时有多个合适的卵,人为的控制排卵数量和成熟时间,这样可以保证成功取出多个卵,提高试管婴儿的成功率。
用什么药促排卵
主要用促性腺激素,正常人体内就有这种激素,但水平会比较低,只能促使一个卵泡发育成熟。做试管婴儿时,给女性注射促性腺激素,人为地提高这种激素水平,促使多个卵泡发育。当女性的卵巢储备充足时,可以一次取到十几个或几十个卵;当储备不足时,不仅需要大量的药物,而且很难刺激出满意的卵泡数。
这种激素属于短效药,每天注射一次,根据卵泡生长情况,一般注射8-15天,有些可能用更长时间。连续注射激素有没有副作用
促性腺激素(主要是FSH和LH等)是人体本身就有的,年轻的时候体内水平比较低。随年龄增加,体内这种激素水平自然上升。特别是绝经期以后的水平,能达到年轻时的几十倍,但更年期女性并不会因此得病。
也就是说,促性腺激素对人没有太大的伤害。但是有些年轻或是有多囊卵巢倾向的女性,对促性腺激素表现出高度的敏感,用药后大量卵泡生长,取卵后还可能发生卵巢过度刺激综合征。
试管婴儿的费用
国内试管婴儿费用大体在3-5万,这是一个取卵周期的费用。
1、若一次促排、一次取卵、鲜胚移植一次成功,费用相对低点,但加上前期的治疗、检查费用,也不会少于3万。
2、若一次移植失败,还有冻胚可移植,每次一万元,两次2万,故一个取卵周期成功的费用大体在3-5万元。
3、若多次失败,多次促排的,需乘以促排次数,两次在6-10万、三次在9-15万,以此类推。
4、另外因精子不好,需做二代试管的,每次取卵周期需多加5千元;因遗传疾病需筛查男女及染色体异常的,要做三代试管,每次取卵周期筛查的费用在5-10万元不等。